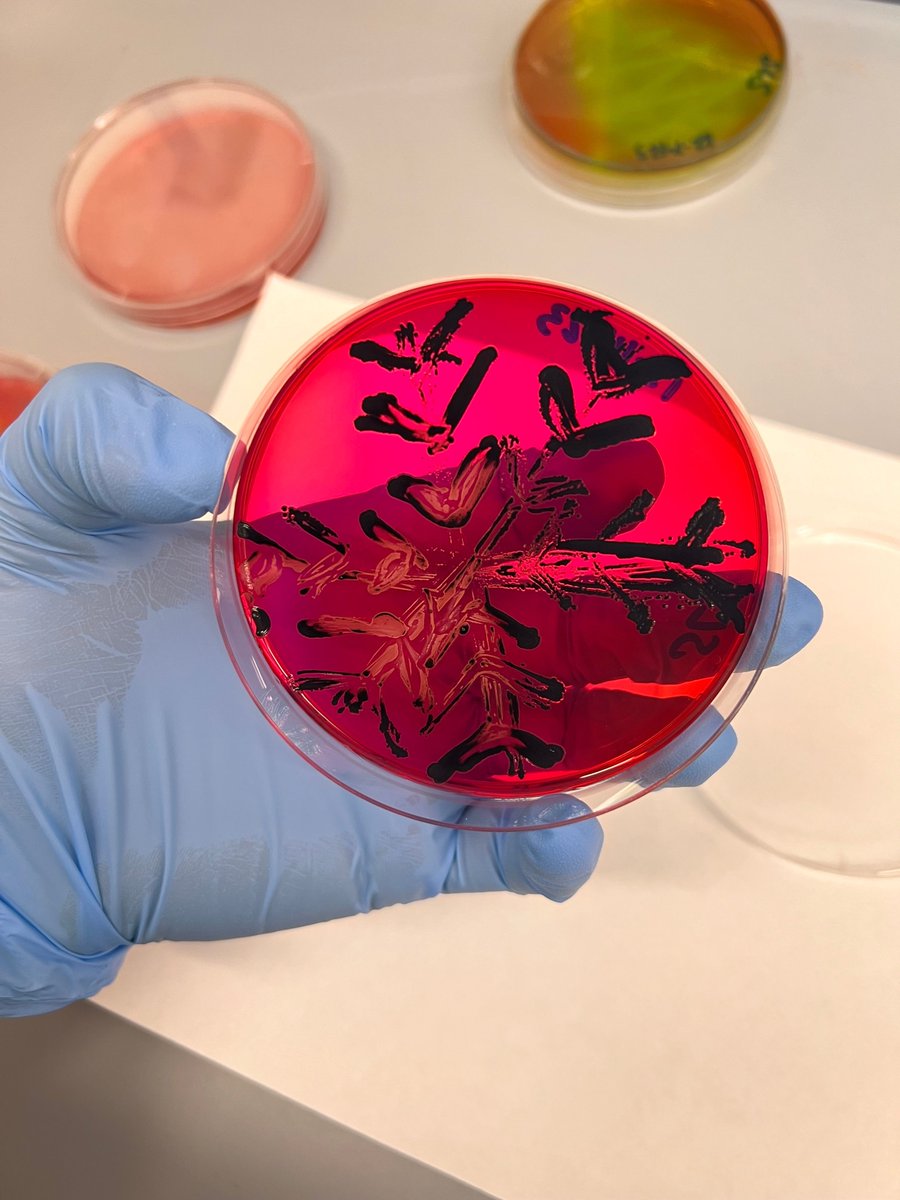
What do you do when you have extra media plates that need to be used up before the winter break? Create super fun holiday-themed bacteria plates! Check out some of the fun creations some members of the Ganda Lab came up with using differentiation media and specific bacteria!

Ganda Lab
@ganda_lab
Account for the Ganda Lab at Penn State
ID: 1320748170092175363
http://www.gandalab.org 26-10-2020 15:24:51
102 Tweet
168 Takipçi
68 Takip Edilen

Dr. Erika Ganda Ganda Lab Ana Fonseca PSUAgScienceResearch Huck Institutes Wish we were there and huge congrats Ana Fonseca Dr. Erika Ganda lab!!









Another round of meeting amazing scientists and developing collaborative projects with USP - Universidade de São Paulo! Of course we must have bovine smooches, data sharing and career development in the mix!


There goes another One Health Microbiome Center Executive Committee leader and scientist changing the world. 🌎👩🏻🏫